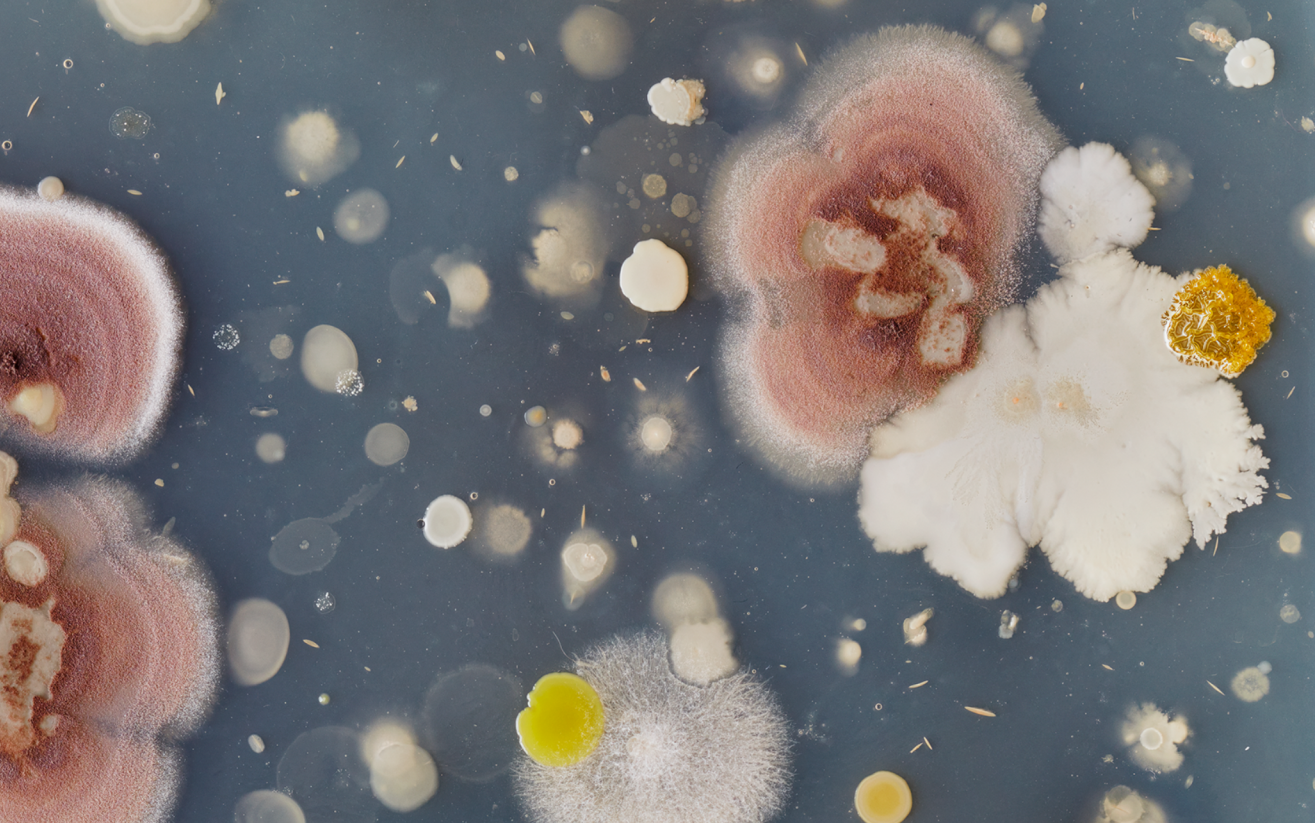
Colourful microbial cultures in a petri dish, forming abstract, textured landscapes.

Microscopic Landscapes & Hidden Perspectives: School of Art Gallery Presents Two Exhibitions by Jon Sasaki
Jon Sasaki: Homage & I Contain Multitudes
February 27 to April 26, 2025
Opening Reception: Thursday, February 27, 5:00–8:00 PM
Artist Talk: Thursday, February 27, 12:00–1:30 PM, 368 ARTlab
School of Art Gallery, University of Manitoba
The School of Art Gallery is pleased to present two interconnected exhibitions by acclaimed Canadian artist Jon Sasaki. These thought-provoking works explore the intersections of art, history, and the unseen landscapes embedded within Canadian art legacies.
Jon Sasaki: Homage
Curated by Sarah Milroy
Organized and circulated by the McMichael Canadian Art Collection
Homage is a suite of large-scale photographs depicting petri dishes containing microbial cultures swabbed from the palettes and brushes of the Group of Seven and Tom Thomson—artifacts housed in the McMichael Canadian Art Collection archives. Sasaki’s glowing bacterial landscapes reframe the genre of landscape painting through the lens of photography, offering a playful yet reverent engagement with the Group’s legacy. This iteration of Homage will debut a new commissioned work derived from holdings in the FitzGerald Study Centre Collection, further linking contemporary artistic practice with Canada’s art historical past.
Exhibition Sponsors: Richard and Donna Ivey
Supported by: Contact Photography Festival
Presented in Partnership with: FLASH Photographic Festival
Jon Sasaki: I Contain Multitudes
Curated by Blair Fornwald
Commissioned by the School of Art Gallery
A newly commissioned body of work, I Contain Multitudes extends Sasaki’s exploration of Canadian art history by engaging directly with the extensive collection of Group of Seven artist and former School of Art Director Lionel LeMoine FitzGerald. Inspired by FitzGerald’s delicate, strangely anthropomorphic tree renderings, Sasaki uses an endoscopic camera to document the hidden interiors of trees around FitzGerald’s former Winnipeg residence and driftwood from the beach near the FitzGerald family cottage on Bowen Island, British Columbia. These intimate and unsettling video landscapes challenge traditional notions of the artistic gaze, oscillating between scientific inquiry and aesthetic discovery.
Presented in Partnership with: FLASH Photographic Festival
Experience the Exhibitions
Join us for the artist talk and opening reception to experience these striking exhibitions firsthand. For more details, visit: umanitoba.ca/art/gallery
Contact Us:
School of Art Gallery
255 ARTlab, 180 Dafoe Road
University of Manitoba (Fort Garry campus)
Winnipeg, MB R3T 2N2
Gallery Hours:
Monday–Friday, 9:00 AM–5:00 PM
Or by appointment. Closed all statutory holidays.
Email: gallery@umanitoba.ca
Phone: 204-474-9322






